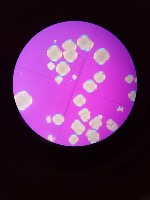

Grumos_IS Computer Vision Project
TRY THIS MODEL
Drop an image or
Trained Model API
This project has a trained model available that you can try in your browser and use to get predictions via our Hosted Inference API and other deployment methods.
Cite This Project
If you use this dataset in a research paper, please cite it using the following BibTeX:
@misc{
grumos_is_dataset,
title = { Grumos_IS Dataset },
type = { Open Source Dataset },
author = { Chamilo BI },
howpublished = { \url{ https://universe.roboflow.com/chamilo-bi-mo2bl/grumos_is } },
url = { https://universe.roboflow.com/chamilo-bi-mo2bl/grumos_is },
journal = { Roboflow Universe },
publisher = { Roboflow },
year = { 2023 },
month = { sep },
note = { visited on 2024-06-03 },
}
Connect Your Model With Program Logic
Find utilities and guides to help you start using the Grumos_IS project in your project.
Similar Projects
fungos
200 images
sperm
111 images
Yeast-IDBg
32 images
Yeast
26 images
wbcr
98 images